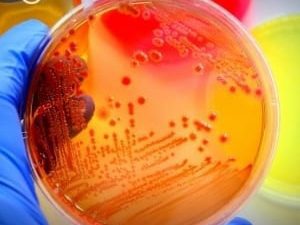

UExcel Test Prep
Anatomy & Physiology Monthly $69.00
Anatomy & Physiology Corresponds to an introductory, two-semester sequence of courses in anatomy and physiology. The course covers knowledge an...
$179
College Credit by Examination
Microbiology Corresponds to an introductory, one-semester course in microbiology. Tests for knowledge and understanding of bacteria, algae, fungi, ...
$179
College Credit by Examination
Lifespan Developmental Psychology Lifespan Development Psychology can be used as a study resource, for professional development, or to earn college...
$29.95